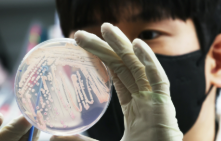
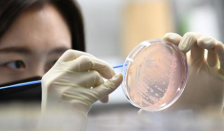

최근 충북, 세종, 전북 부안 등 전국 학교·유치원 급식에서 제공된 빵을 먹고 구토, 설사 등 집단 식중독 증상이 속출하고 있습니다. 식중독 원인은 살모넬라균으로 확인됐으며, 문제가 된 제품은 풀무원 계열 푸드머스가 유통·판매한 ‘고칼슘 딸기크림 롤케이크’와 ‘고칼슘 우리밀 초코바나나빵’입니다. 유증상자는 208명으로 집계됐으며, 식약처는 즉시 판매 중단·회수 조치에 나섰습니다.
🧁 집단 식중독 발생 현황
- 최초 발생: 5월 15일 충북 청주·진천 학교·유치원 급식소(청주 120명, 진천 35명)
- 추가 확산: 세종(18명), 전북 부안(35명) 등 전국 4건 확인
- 누적 유증상자: 총 208명(6월 13일 기준)
- 증상: 구토, 설사, 복통, 발열 등 살모넬라 식중독 전형적 증상



🔎 원인 제품·유통 경로
- 문제 제품: 고칼슘 딸기크림 롤케이크(소비기한 2025.10.12), 고칼슘 우리밀 초코바나나빵(소비기한 2025.9.21)
- 제조: 마더구스 / 유통·판매: 풀무원 계열 푸드머스
- 전국 학교·유치원 등 급식사업장에 약 2만 7천개 납품
- 식약처, 6월 5일 두 제품 판매 중단 및 전량 회수 조치
푸드머스는 식중독 의심 신고 즉시 납품 중단, 자진 회수·폐기했다고 밝혔습니다.



🦠 살모넬라균 감염, 증상과 예방
- 살모넬라균은 오염된 음식(특히 달걀, 가금류, 유가공품, 빵류 등) 섭취 시 감염
- 주요 증상: 구토, 설사, 복통, 발열, 두통 등(보통 6~72시간 내 증상 발현)
- 예방: 음식은 중심온도 75℃ 이상 1분 이상 가열, 손 씻기 철저히, 달걀·빵류 등은 신선도·보관상태 확인
식중독 의심 증상(설사, 구토 등) 발생 시 즉시 병원 진료, 같은 기관에서 2명 이상 유증상자 발생 시 보건소 신고 필요합니다.

🚨 당국 조치 및 추가 모니터링
- 식약처, 문제 제품 판매 중단·회수·폐기 조치
- 질병관리청, 전국 납품시설 추가 유증상자 모니터링 중
- 방역당국, “제품 섭취 후 증상 시 병원 진료, 2명 이상 유증상자 발생 시 즉시 보건소 신고” 당부
학교·유치원 등 집단급식 시설은 식자재 납품 내역, 보관·조리 위생 점검을 강화해야 하며, 학부모·교직원은 식중독 예방수칙을 철저히 지켜야 합니다.

💡 소비자 주의사항 및 꿀팁
- 문제 제품(고칼슘 딸기크림 롤케이크, 고칼슘 우리밀 초코바나나빵) 소비기한·제조사 반드시 확인
- 식중독 의심 증상 시 병원 진료, 납품처·학교·보건소에 즉시 신고
- 식품 보관·조리 위생, 손 씻기 등 개인위생 철저히
유사 증상·제품 발견 시 식약처, 질병관리청, 학교·보건소로 즉시 제보 바랍니다.
소원이 이루어진다는 단양 구인사, 5층 대법당·천태종 총본산 완벽 가이드
충북 단양 소백산 기슭에 자리한 구인사는 대한불교 천태종의 총본산이자, 전국 140여 개 사찰을 관장하는 중심 도량입니다. 해발 1,000m가 넘는 연화봉 아래, 장엄한 자연과 현대 불교 건축이 어
plus.fingerplay.co.kr
정선 덕우리 청보리밭, 인생사진·기념품·웨딩포토존까지 초여름 SNS 명소
“그냥 소풍 간 건데 인생사진 나온다”… 기념품도 주는 초여름 청보리 명소, 정선 덕우리 청보리밭초여름, 강원도 정선의 덕우리 청보리밭은 초록빛 물결과 특별한 포토존, 그리고 SNS 인증 이
plus.fingerplay.co.kr
평창 육백마지기 샤스타데이지 절정, 6월 하얀 꽃물결과 풍력발전기 여행 가이드
탁 트인 고원, 바람 따라 흐르는 초원, 그리고 하늘과 맞닿은 풍경. 강원도 평창의 청옥산 육백마지기는 ‘한국의 알프스’로 불릴 만큼 드라마틱한 자연미를 자랑하는 대표 힐링 여행지입니다.
plus.fingerplay.co.kr